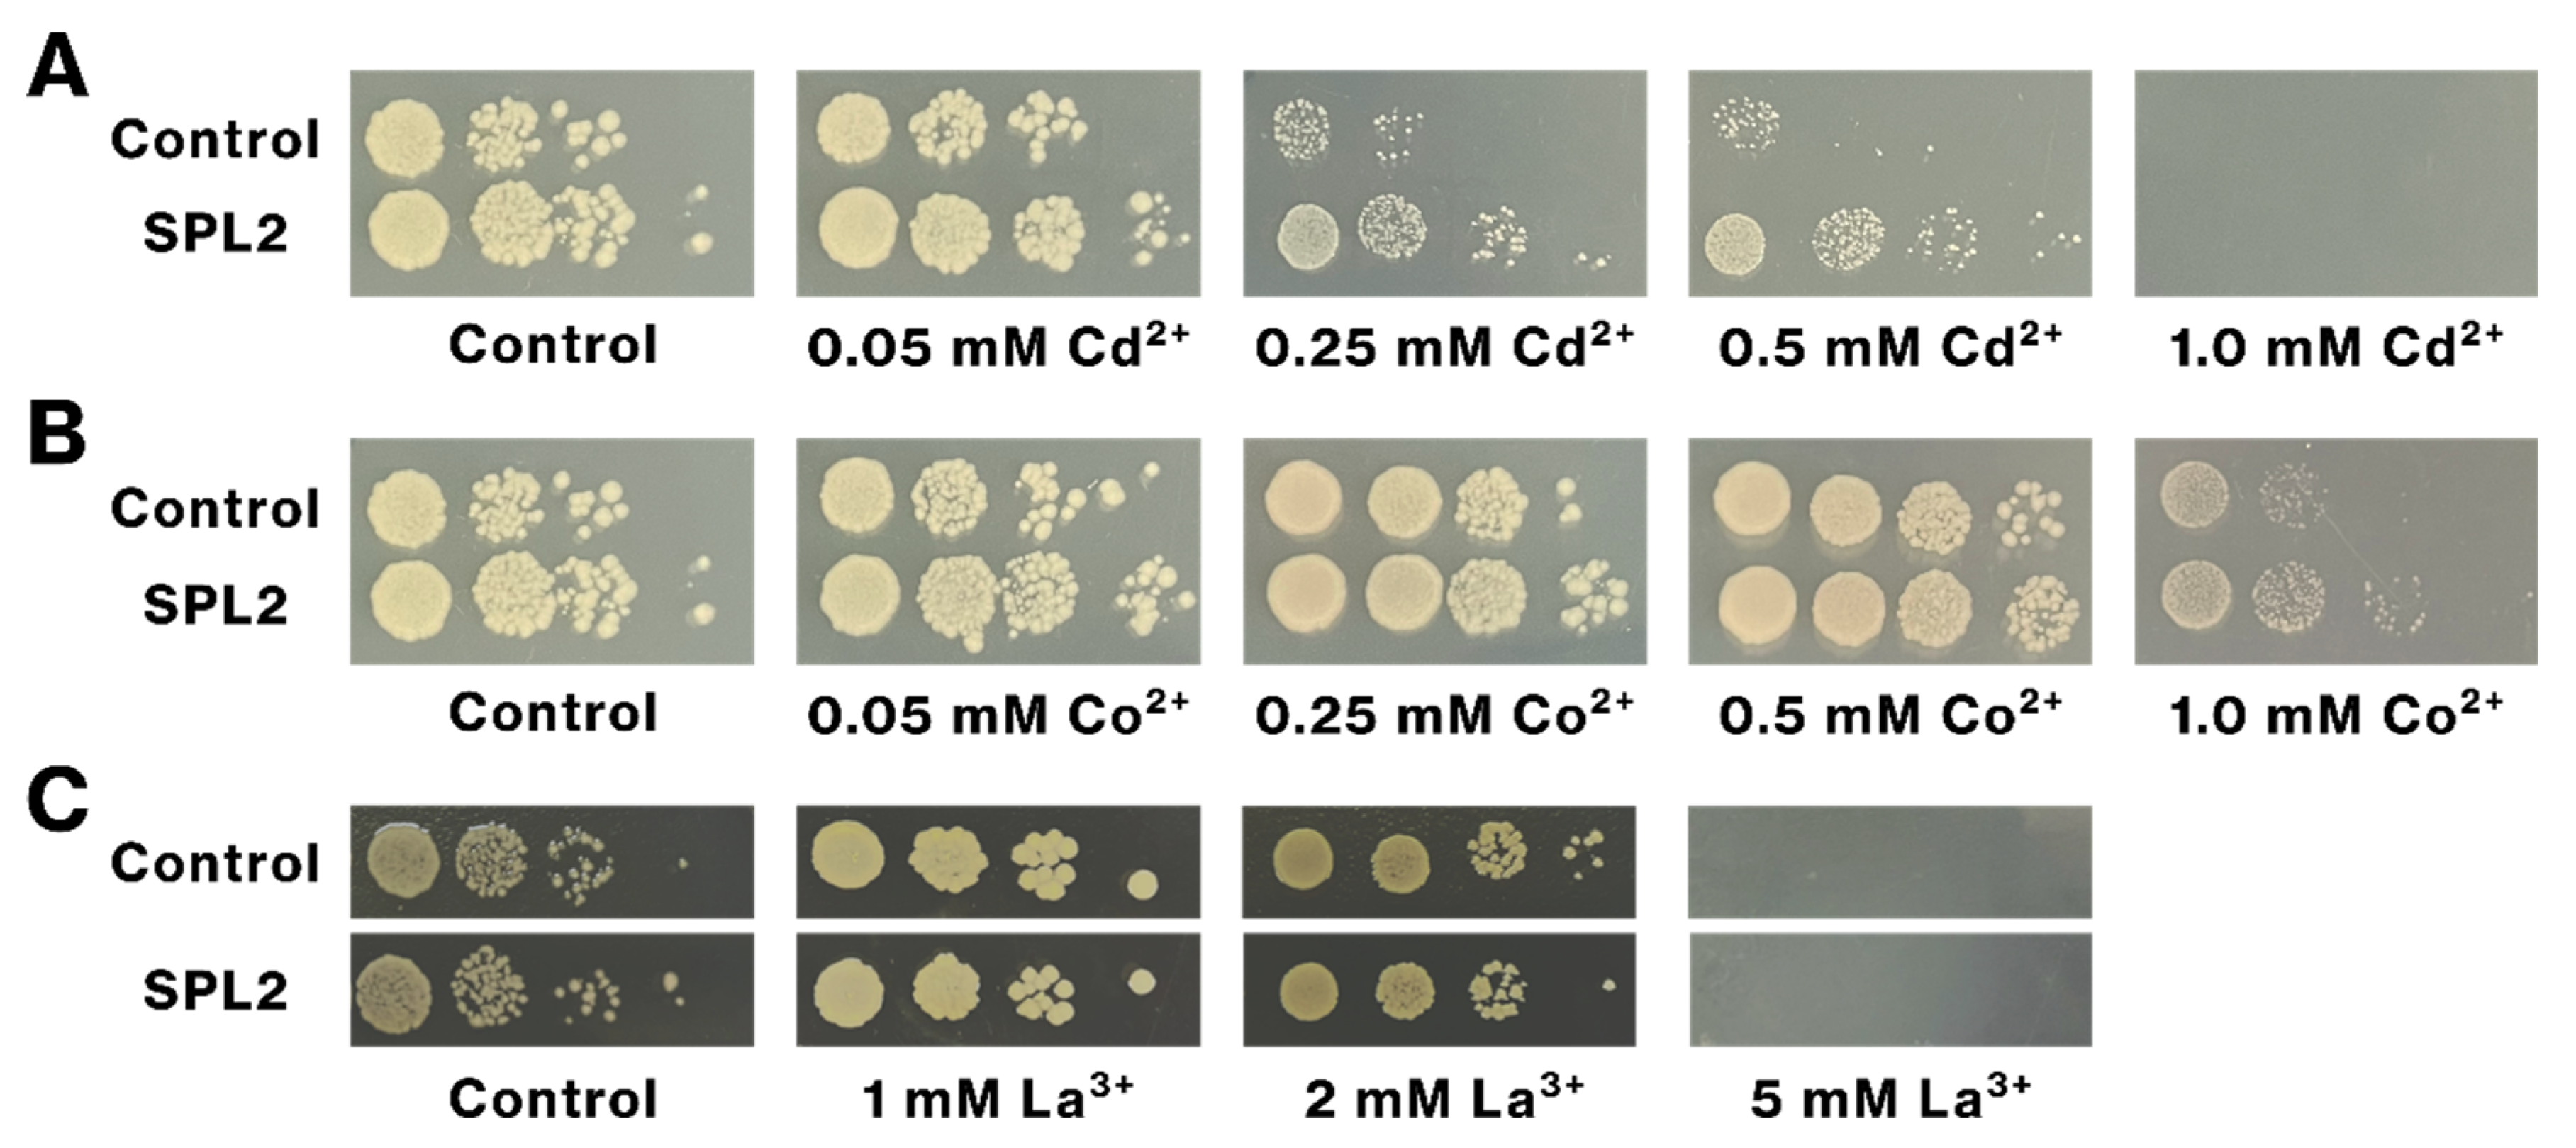
Ijms 26 01905 g008

Evaluation of Metal Accumulation in Escherichia coli Expressing SPL2 by Single-Cell Inductively Coupled Plasma Mass Spectrometry
Abstract
1. Introduction
2. Results
2.1. SPL2 and Lanpepsy Show High Expression and Solubility in Bacteria
2.2. SPL2 Promotes La Binding in Recombinant Bacteria
2.3. SPL2 Enhances Transition Metal Binding in Recombinant Bacteria
2.4. La and Cd Sequestration in SPL2-Expressing Bacteria
2.5. SPL2 Expression Increases Cd Tolerance of Recombinant Bacteria
3. Discussion
4. Materials and Methods
4.1. Plasmid Vectors
4.2. Expression and Solubility of Recombinant Proteins
4.3. E. coli Preparation for scICP-MS Analysis
4.4. Metal Analysis of Recombinant Bacteria by scICP-MS
4.5. Heavy Metal Tolerance of SPL2-Expressing Bacteria
4.6. Removal of Heavy Metals by SPL2-Expressing Bacteria
5. Conclusions
Supplementary Materials
Author Contributions
Funding
Institutional Review Board Statement
Informed Consent Statement
Data Availability Statement
Acknowledgments
Conflicts of Interest
References
- Kowalkowski, T.; Pastuszak, M.; Szparaga, A.; Samczynski, Z.; Polkowska-Motrenko, H.; Buszewski, B. Rare earth elements in fine fraction (<20 mum) of the Vistula River sediments. Chemosphere 2019, 237, 124442. [Google Scholar] [PubMed]
- Zepf, V. Rare Earth Elements: A New Approach to the Nexus of Supply, Demand and Use: Exemplified along the Use of Neodymium in Permanent Magnets; Springer: Berlin/Heidelberg, Germany, 2013. [Google Scholar]
- Dushyantha, N.; Batapola, N.; Ilankoon, I.M.S.K.; Rohitha, S.; Premasiri, R.; Abeysinghe, B.; Ratnayake, N.; Dissanayake, K. The story of rare earth elements (REEs): Occurrences, global distribution, genesis, geology, mineralogy and global production. Ore Geol. Rev. 2020, 122, 103521. [Google Scholar] [CrossRef]
- Balaram, V. Rare earth elements: A review of applications, occurrence, exploration, analysis, recycling, and environmental impact. Geosci. Front. 2019, 10, 1285–1303. [Google Scholar] [CrossRef]
- Gwenzi, W.; Mangori, L.; Danha, C.; Chaukura, N.; Dunjana, N.; Sanganyado, E. Sources, behaviour, and environmental and human health risks of high-technology rare earth elements as emerging contaminants. Sci. Total Environ. 2018, 636, 299–313. [Google Scholar] [CrossRef]
- Wang, Z.; Zhang, X.; Mu, Y. Effects of rare-earth fertilizers on the emission of nitrous oxide from agricultural soils in China. Atmos. Environ. 2008, 42, 3882–3887. [Google Scholar] [CrossRef]
- Basu, A.; Chakrabarty, K.; Chatterjee, G.C. Neurotoxicity of lanthanum chloride in newborn chicks. Toxicol. Lett. 1982, 14, 21–25. [Google Scholar] [CrossRef]
- Palasz, A.; Czekaj, P. Toxicological and cytophysiological aspects of lanthanides action. Acta Biochim. Pol. 2000, 47, 1107–1114. [Google Scholar] [CrossRef]
- Feng, L.; Xiao, H.; He, X.; Li, Z.; Li, F.; Liu, N.; Zhao, Y.; Huang, Y.; Zhang, Z.; Chai, Z. Neurotoxicological consequence of long-term exposure to lanthanum. Toxicol. Lett. 2006, 165, 112–120. [Google Scholar] [CrossRef]
- Xie, X.; Tan, X.; Yu, Y.; Li, Y.; Wang, P.; Liang, Y.; Yan, Y. Effectively auto-regulated adsorption and recovery of rare earth elements via an engineered E. coli. J. Hazard. Mater. 2022, 424, 127642. [Google Scholar] [CrossRef]
- Abashina, T.; Vainshtein, M. Current Trends in Metal Biomining with a Focus on Genomics Aspects and Attention to Arsenopyrite Leaching-A Review. Microorganisms 2023, 11, 186. [Google Scholar] [CrossRef]
- Liapun, V.; Motola, M. Current overview and future perspective in fungal biorecovery of metals from secondary sources. J. Environ. Manag. 2023, 332, 117345. [Google Scholar] [CrossRef] [PubMed]
- Park, D.M.; Reed, D.W.; Yung, M.C.; Eslamimanesh, A.; Lencka, M.M.; Anderko, A.; Fujita, Y.; Riman, R.E.; Navrotsky, A.; Jiao, Y. Bioadsorption of Rare Earth Elements through Cell Surface Display of Lanthanide Binding Tags. Environ. Sci. Technol. 2016, 50, 2735–2742. [Google Scholar] [CrossRef] [PubMed]
- Park, D.M.; Brewer, A.; Reed, D.W.; Lammers, L.N.; Jiao, Y. Recovery of Rare Earth Elements from Low-Grade Feedstock Leachates Using Engineered Bacteria. Environ. Sci. Technol. 2017, 51, 13471–13480. [Google Scholar] [CrossRef] [PubMed]
- Martin, K.; Hosam, M.S. Introductory Chapter: Introducing Heavy Metals. In Heavy Metals; Hosam El-Din, M.S., Refaat, F.A., Eds.; IntechOpen: Rijeka, Croatia, 2018; pp. 3–11. [Google Scholar]
- Vhahangwele, M.; Khathutshelo, L.M. Environmental Contamination by Heavy Metals. In Heavy Metals; Hosam El-Din, M.S., Refaat, F.A., Eds.; IntechOpen: Rijeka, Croatia, 2018; pp. 115–133. [Google Scholar]
- Armah, F.A.; Obiri, S.; Yawson, D.O.; Onumah, E.E.; Yengoh, G.T.; Afrifa EK, A.; Odoi, J.O. Anthropogenic sources and environmentally relevant concentrations of heavy metals in surface water of a mining district in Ghana: A multivariate statistical approach. J. Environ. Sci. Health A 2010, 45, 1804–1813. [Google Scholar] [CrossRef]
- Razzak, S.A.; Faruque, M.O.; Alsheikh, Z.; Alsheikhmohamad, L.; Alkuroud, D.; Alfayez, A.; Hossain SM, Z.; Hossain, M.M. A comprehensive review on conventional and biological-driven heavy metals removal from industrial wastewater. Environ. Adv. 2022, 7, 100168. [Google Scholar] [CrossRef]
- Ramya, S.L.; Vinay Kumar, C.; Sudhamani, M. Application of Biosorption for Removal of Heavy Metals from Wastewater. In Biosorption; Jan, D., Branislav, V., Eds.; IntechOpen: Rijeka, Croatia, 2018. [Google Scholar]
- Liu, S.H.; Zeng, G.M.; Niu, Q.Y.; Liu, Y.; Zhou, L.; Jiang, L.H.; Tan, X.F.; Xu, P.; Zhang, C.; Cheng, M. Bioremediation mechanisms of combined pollution of PAHs and heavy metals by bacteria and fungi: A mini review. Bioresour. Technol. 2017, 224, 25–33. [Google Scholar] [CrossRef]
- Znad, H.; Awual, M.R.; Martini, S. The Utilization of Algae and Seaweed Biomass for Bioremediation of Heavy Metal-Contaminated Wastewater. Molecules 2022, 27, 1275. [Google Scholar] [CrossRef]
- Salama, E.S.; Roh, H.S.; Dev, S.; Khan, M.A.; Abou-Shanab RA, I.; Chang, S.W.; Jeon, B.H. Algae as a green technology for heavy metals removal from various wastewater. World J. Microbiol. Biotechnol. 2019, 35, 75. [Google Scholar] [CrossRef]
- Arumugam, N.; Chelliapan, S.; Kamyab, H.; Thirugnana, S.; Othman, N.; Nasri, N.S. Treatment of Wastewater Using Seaweed: A Review. Int. J. Environ. Res. Public Health 2018, 15, 2851. [Google Scholar] [CrossRef]
- Alabssawy, A.N.; Hashem, A.H. Bioremediation of hazardous heavy metals by marine microorganisms: A recent review. Arch. Microbiol. 2024, 206, 103. [Google Scholar] [CrossRef]
- Roy, R.; Samanta, S.; Pandit, S.; Naaz, T.; Banerjee, S.; Rawat, J.M.; Chaubey, K.K.; Saha, R.P. An Overview of Bacteria-Mediated Heavy Metal Bioremediation Strategies. Appl. Biochem. Biotechnol. 2024, 196, 1712–1751. [Google Scholar] [CrossRef] [PubMed]
- Zheng, Y.; Xiao, C.; Chi, R. Remediation of soil cadmium pollution by biomineralization using microbial-induced precipitation: A review. World J. Microbiol. Biotechnol. 2021, 37, 208. [Google Scholar] [CrossRef] [PubMed]
- Anand, S.; Singh, A.; Kumar, V. Recent advancements in cadmium-microbe interactive relations and their application for environmental remediation: A mechanistic overview. Environ. Sci. Pollut. Res. Int. 2023, 30, 17009–17038. [Google Scholar] [CrossRef]
- Hansda, A.; Kumar, V.; Anshumali. A comparative review towards potential of microbial cells for heavy metal removal with emphasis on biosorption and bioaccumulation. World J. Microbiol. Biotechnol. 2016, 32, 170. [Google Scholar] [CrossRef]
- Saravanan, A.; Kumar, P.S.; Ramesh, B.; Srinivasan, S. Removal of toxic heavy metals using genetically engineered microbes: Molecular tools, risk assessment and management strategies. Chemosphere 2022, 298, 134341. [Google Scholar] [CrossRef]
- Tian, L.; Wang, D.; Liu, Y.; Wei, M.; Han, X.; Sun, X.; Yin, L.; Luo, G. Construction of Genetically Engineered Escherichia coli Cell Factory for Enhanced Cadmium Bioaccumulation in Wastewater. Water 2024, 16, 1759. [Google Scholar] [CrossRef]
- Tracz, M.; Gorniak, I.; Szczepaniak, A.; Bialek, W. E3 Ubiquitin Ligase SPL2 Is a Lanthanide-Binding Protein. Int. J. Mol. Sci. 2021, 22, 5712. [Google Scholar] [CrossRef]
- Cotruvo, J.A.; Jr Featherston, E.R.; Mattocks, J.A.; Ho, J.V.; Laremore, T.N. Lanmodulin: A Highly Selective Lanthanide-Binding Protein from a Lanthanide-Utilizing Bacterium. J. Am. Chem. Soc. 2018, 140, 15056–15061. [Google Scholar] [CrossRef]
- Hemmann, J.L.; Keller, P.; Hemmerle, L.; Vonderach, T.; Ochsner, A.M.; Bortfeld-Miller, M.; Gunther, D.; Vorholt, J.A. Lanpepsy is a novel lanthanide-binding protein involved in the lanthanide response of the obligate methylotroph Methylobacillus flagellatus. J. Biol. Chem. 2023, 299, 102940. [Google Scholar] [CrossRef]
- Meyer, S.; Lopez-Serrano, A.; Mitze, H.; Jakubowski, N.; Schwerdtle, T. Single-cell analysis by ICP-MS/MS as a fast tool for cellular bioavailability studies of arsenite. Metallomics 2018, 10, 73–76. [Google Scholar] [CrossRef]
- Ho, K.-S.; Chan, W.-T. Time-resolved ICP-MS measurement for single-cell analysis and on-line cytometry. J. Anal. At. Spectrom. 2010, 25, 1114–1122. [Google Scholar] [CrossRef]
- Tanaka, Y.; Iida, R.; Takada, S.; Kubota, T.; Yamanaka, M.; Sugiyama, N.; Abdelnour, Y.; Ogra, Y. Quantitative Elemental Analysis of a Single Cell by Using Inductively Coupled Plasma-Mass Spectrometry in Fast Time-Resolved Analysis Mode. Chembiochem 2020, 21, 3266–3272. [Google Scholar] [CrossRef] [PubMed]
- Tanaka, Y.; Katayama, H.; Iida, R.; Ogra, Y. Quantitative elemental analysis of human leukemia K562 single cells by inductively coupled plasma mass spectrometry in combination with a microdroplet generator. J. Anal. At. Spectrom. 2025, 40, 216–225. [Google Scholar] [CrossRef]
- Ogra, Y.; Tanaka, Y.; Suzuki, N. Recent advances in copper analyses by inorganic mass spectrometry. J. Clin. Biochem. Nutr. 2022, 71, 2–6. [Google Scholar] [CrossRef]
- Tanaka, Y.; Shimazaki, S.; Fukumoto, Y.; Ogra, Y. Detection of Histidine-Tagged Protein in Escherichia coli by Single-Cell Inductively Coupled Plasma-Mass Spectrometry. Anal. Chem. 2022, 94, 7952–7959. [Google Scholar] [CrossRef]
- Kaczorowska, M.A. The Use of Polymer Inclusion Membranes for the Removal of Metal Ions from Aqueous Solutions-The Latest Achievements and Potential Industrial Applications: A Review. Membranes 2022, 12, 1135. [Google Scholar] [CrossRef]
- Fukumoto, Y.; Kyono, R.; Shibukawa, Y.; Tanaka, Y.; Suzuki, N.; Ogra, Y. Differential molecular mechanisms of substrate recognition by selenium methyltransferases, INMT and TPMT, in selenium detoxification and excretion. J. Biol. Chem. 2024, 300, 105599. [Google Scholar] [CrossRef]
- Fukumoto, Y.; Nakayama, Y.; Yamaguchi, N. Human Rad17 C-terminal tail is phosphorylated by concerted action of CK1delta/epsilon and CK2 to promote interaction with the 9-1-1 complex. Biochem. Biophys. Res. Commun. 2019, 517, 310–316. [Google Scholar] [CrossRef]

| Instrument | Agilent 8900 ICP-MS/MS |
|---|---|
| ICP incident power | 1600 W |
| Ar carrier gas | 0.60 L/min |
| Make-up gas | 0.25 L/min |
| Integration time | 0.1 ms |
| Collision/reaction cell | H2: 5.5 mL/min (La, Tb, Cd, Ni, Co, Si) |
| O2: 0.38 mL/min (P) | |
| Signal monitoring period | 40 s |
| Sample injection rate | 0.015 mL/min |
Disclaimer/Publisher’s Note: The statements, opinions and data contained in all publications are solely those of the individual author(s) and contributor(s) and not of MDPI and/or the editor(s). MDPI and/or the editor(s) disclaim responsibility for any injury to people or property resulting from any ideas, methods, instructions or products referred to in the content. |
© 2025 by the authors. Licensee MDPI, Basel, Switzerland. This article is an open access article distributed under the terms and conditions of the Creative Commons Attribution (CC BY) license (https://creativecommons.org/licenses/by/4.0/).
Share and Cite
Fukumoto, Y.; Li, E.; Tanaka, Y.-k.; Suzuki, N.; Ogra, Y. Evaluation of Metal Accumulation in Escherichia coli Expressing SPL2 by Single-Cell Inductively Coupled Plasma Mass Spectrometry. Int. J. Mol. Sci. 2025, 26, 1905. https://doi.org/10.3390/ijms26051905
Fukumoto Y, Li E, Tanaka Y-k, Suzuki N, Ogra Y. Evaluation of Metal Accumulation in Escherichia coli Expressing SPL2 by Single-Cell Inductively Coupled Plasma Mass Spectrometry. International Journal of Molecular Sciences. 2025; 26(5):1905. https://doi.org/10.3390/ijms26051905
Chicago/Turabian StyleFukumoto, Yasunori, Enhui Li, Yu-ki Tanaka, Noriyuki Suzuki, and Yasumitsu Ogra. 2025. "Evaluation of Metal Accumulation in Escherichia coli Expressing SPL2 by Single-Cell Inductively Coupled Plasma Mass Spectrometry" International Journal of Molecular Sciences 26, no. 5: 1905. https://doi.org/10.3390/ijms26051905
APA StyleFukumoto, Y., Li, E., Tanaka, Y.-k., Suzuki, N., & Ogra, Y. (2025). Evaluation of Metal Accumulation in Escherichia coli Expressing SPL2 by Single-Cell Inductively Coupled Plasma Mass Spectrometry. International Journal of Molecular Sciences, 26(5), 1905. https://doi.org/10.3390/ijms26051905

